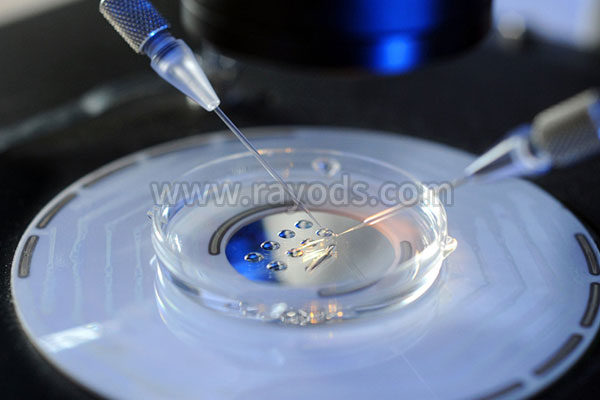
试管婴儿究竟会对女性身体造成哪些影响危害？

-

后定诺会对身体有副作用吗?
后定诺是避孕的普遍药品,许多女士都是会挑选后定诺来开展避孕,可是呢,服用药品是有一定的副作用,因此服用后定诺有什么不良反应呢?下面就来为大伙儿了解一下,也期待可..
2022-11-23 14:16 -
胎教会对胎儿产生哪些积极影响
范畴的胎教就是指依据胎儿各视觉器官生长发育发展的具体情况,科学研究地出示视觉效果、听觉系统、触感等层面的刺激性,如阳光照射、歌曲、会话、敲打、抚摩等,以最大限度..
2023-01-28 14:00 -
子宫纵隔是先第三代试管还是手术?不手术纵隔会对着床产生影响吗?
子宫纵隔是先第三代试管还是手术?不手术纵隔会对着床产生影响吗?我现在是子宫畸形,不全纵隔,还查了激素,现在泌乳素高36.62,监测过一期排卵,卵泡长不大,内膜最高0.6..
2023-04-08 12:58 -

孕妇患有妊娠合并糖尿病会对对孕妇和胎儿产生的影响
从科学研究的视角表述,妊娠合并糖尿病就是指在原来糖尿病的基本上合并妊娠。包含糖尿病病人妊娠和妊娠期初次发生糖尿病,又叫妊娠期糖尿病。妊娠合并糖尿病对孕妇和胎儿的..
2023-04-13 10:09 -

请了和合符对方会怎样,和合符不会对对方的身体起负面影响
不少想请符的朋友会担心,请了和合符对方会怎样。我有一个朋友是做玄学方面的。他告诉我们,其实正统的和合符不会对请符人,挽回人的身体起负面的影响。若请的不是正规的符..
2023-04-16 07:26 -
血糖高能取卵吗(血糖高会对试管婴儿促排卵有影响吗)
血糖高能献血吗1、高血糖患者不应献血。目前,医学水平还不能完全治愈高血糖症状。药物只能用来控制症状,但不能完全治疗。一旦转化高血糖患者成为糖尿病,将成为终身代谢..
2023-04-17 07:49 -

什么疾病会对生育产生负面影响呢
如今的社会,环境污染、食品污染问题层出不群。许多人工作压力过大,生活不规律,十分容易导致一些病症。下面将介绍一些可能对生育造成不利影响的病症。1、甲状腺功能障碍..
2023-06-05 10:20 -

为什么还有人研究前生?真的会对个人有影响吗
阴债每个人都有,只是有点人比较轻,对于我们的影响不是很明显,如果是影响比较重的话,那么影响就会比较严重,每个人都想要好运势,及时还阴债就能获得好运势,这就是为何..
2023-08-01 07:07 -
产后做梦总是梦到雪天是什么原因,会对生活产生什么影响
随着科技的不断进步和社会的不断发展,人们的生活质量逐渐提高,越来越多的女性选择了生育孩子。众所周知,产后恢复是十分重要的,这期间需要照顾好自己的身体和心理,但很..
2023-12-12 14:11 -

忧字要怎么理解,过于忧虑会对生活产生什么影响
一、怎么理解忧忧,又称忧虑、愁,是一种情绪,通常指因为事物的不如意、困难与挫折而引起的心理疾病。忧虑往往包含对未来的担忧与对过去错失的遗憾,会在心理和生理上产生..
2023-12-21 15:39 -

来大姨妈第一天打hpv会对身体有什么影响呢?
来大姨妈第一天打hpv会对身体有什么影响呢? 我今年18岁,我今天去医院打了hpv疫苗,但是回家发现我大姨妈来了,但是我并不知情,请问来大姨妈第一天打hpv会怎样?打HPV疫..
2024-01-09 06:00 -

吃三次避孕药会导致不孕吗 会对身体带来那些危害
避孕药是人工合成的甾体类激素,主要是雌激素和孕激素。吃避孕药是现在大多数选择避孕的方法,频繁服用避孕药会导致体内激素水平的的紊乱,引起月经不调,从而导致不能生育..
2024-03-11 09:09 -
梦见自己进监狱了是什么征兆 梦见自己被送进监狱是否会对未来生活造成影响
梦见自己进监狱是一种很常见的梦境,对于梦境的解释不仅仅只有谈论到特定的事件,更是和人生的方方面面息息相关。因此,在这篇文章中,将会深入探讨这个梦境的不同含义。首..
2024-03-13 11:34 -
试管婴儿究竟会对女性身体造成哪些影响危害?
试管婴儿技术的出现,给许多不孕不育患者带来了新的希望,我们在看到试管婴儿的好处之外,其是否也存在一些危害性呢?我们要知道凡事都有两面性,试管婴儿主要是将卵子与精..
2024-04-09 09:02 -

池州助孕医院提醒大家试管婴儿过程中的促排药会对女性身体产生影响吗?
美国第三代试管婴儿周期中,试管准妈妈们都需要先进行促排周期,这意味着需要在一个月经周期内,通过促排取卵手术,能够获得5-20个左右的卵子。一般人每次月经周期只会成熟..
2024-04-25 09:13 -

多次促排取卵会对身体造成什么伤害?取卵后做好这4点才有利于卵巢恢复
在试管婴儿的促排卵过程中,对于卵巢功能差、促排卵泡数少的患者而言,多次促排取卵是在所难免的。那么,多次促排取卵会对身体造成什么伤害?取卵后怎么做有利于卵巢恢复?..
2024-05-05 09:52 -

俄罗斯试管婴儿取卵过程使用麻药会对卵子或身体有伤害吗?
在俄罗斯试管婴儿周期操作中,取卵手术是女性多天促排用药,最后收获成果的关键一步。在这个至关重要的环节,不少女性也不免会对取卵手术有些紧张情绪。1.为了避免卵子在取..
2024-05-07 09:18 -

怀孕后期总胆汁酸高怎么办?会对宝宝有什么影响?
孕期总胆汁酸高(Pregnancy-Related Cholestasis,简称PRC),是一种孕妇特有的肝胆系统疾病,临床上,对于PRC的治疗一般采用药物治疗和生活方式干预两种方式,药物治疗主..
2024-05-07 09:27 -

孕八月宫颈炎出现宫缩会对宝宝造成影响吗?
宫颈炎对宝宝的影响取决于宫颈炎的严重程度以及孕妇的怀孕期数,而宫颈炎诱发的宫缩只要不是特别频繁,基本不会对宝宝有影响。怀孕八个月的女性此时体质较弱,免疫力和抵抗..
2024-05-14 09:11 -

怎样解决家庭婆媳关系,总结这几个方法,相信会对你有用
我们都明白在中国的大部分家庭里一些不和谐的因素主要是由于婆媳关系之间的不稳定而造成的,那么如何解决婆媳之间的矛盾就成为许多人想要了解了一个问题,其实这个难题也困..
2024-08-08 00:40
微信分享
扫描二维码分享到微信或朋友圈